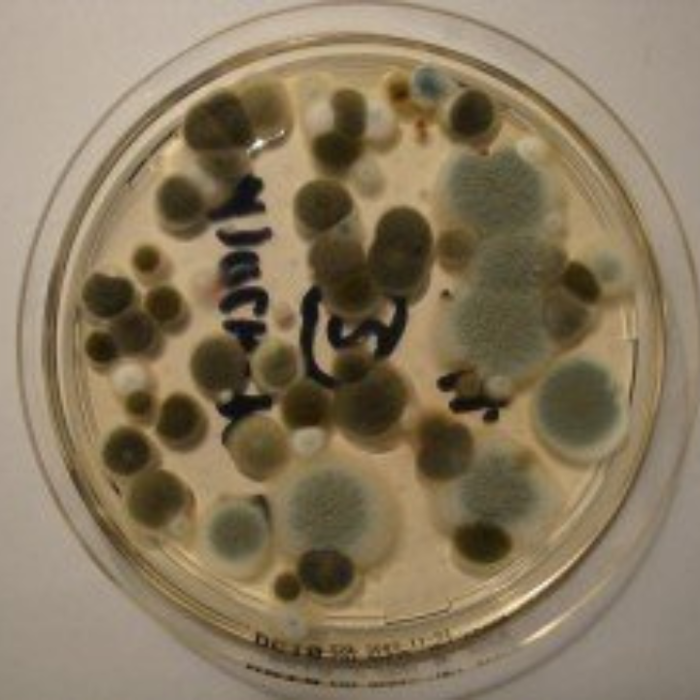
bioCon - Experten für Schimmel, Schädlinge & Co. | Schädlingsbekämpfung Kriegerowski, Kleiststraße in Bernau bei Berlin

bioCon - Experten für Schimmel, Schädlinge & Co. | Schädlingsbekämpfung Kriegerowski
in Bernau bei Berlin
Schädlingsbekämpfung
Adresse
Kleiststraße 916321 Bernau bei Berlin Zur Webseite
Kontakt
Telefonnummer: +49 3338 356948
E-Mail: ivok@biocon.info
Öffnungszeiten
Mo. 08:00 - 17:00Di. 08:00 - 17:00
Mi. 08:00 - 17:00
Do. 08:00 - 17:00
Fr. 08:00 - 17:00
Sa. Geschlossen
So. Geschlossen

Garten- & Landschaftsbau
Garten- & Landschaftsbau